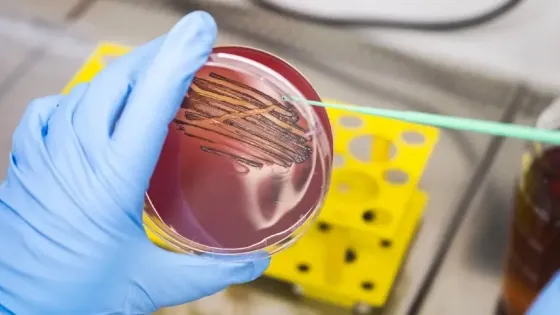
0f15fb6e-68d8-47d4-add9-0fc34566e15f

- Новая зубная паста уничтожает патогенные бактерии, сохраняя микробиоту полости рта.
- Ополаскиватели для ухода за полостью рта уничтожают как патогенные, так и полезные бактерии.
- Ученые из Германии разработали зубную пасту, убивающую только вызывающие пародонтит бактерии.
- Паста основана на открытии вещества, избирательно блокирующего вредные бактерии, такие как porphyromonas gingivalis.
- Вещество подавляет рост бактерий и работает в гармонии со здоровыми бактериями, восстанавливая микробиоту полости рта.
- После применения ополаскивателей патогенные бактерии начинают расти быстрее полезных.
- Авторы работают над совершенствованием состава пасты и созданием защитного геля и ополаскивателя для сохранения баланса микробиоты полости рта.
Новая зубная паста уничтожает только патогенные бактерии, сохраняя микробиоту полости рта
12 янв 2026
Краткий пересказ
от нейросети YandexGPT
Обложка: Изображение из статьи